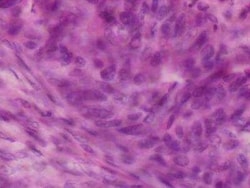
Novus Biologicals Human Breast Tissue Lysate (Adult Normal) 0.1 mg | Buy Online | Novus Biologicals&trade; | Fisher Scientific

missing translation for 'onlineSavingsMsg'
Learn More
Learn More
Spezifikation
Spezifikation
| Preparation Method | These lysates are proteomic discovery tools.Researchers should validate and optimize for individual use. Potential applications MAY include WB, immunoprecipitation, protein-protein interactions, ligand binding, ELISA. Note: For use in 1D and 2D gel electrophoresis, the addition of a denaturing gel loading buffer with reducing agents may be required. |
| Quantity | 0.1 mg |
| Content And Storage | Store at -20°C short term. Aliquot and store at -70°C long term. Avoid freeze-thaw cycles. |
| Target | Breast |
Name des Produkts
Indem Sie auf Absenden klicken, erklären Sie sich damit einverstanden, dass Fisher Scientific sich mit Ihnen in Verbindung setzen kann, um Ihr Feedback in diesem Formular zu bearbeiten. Wir werden Ihre Informationen nicht für andere Zwecke weitergeben. Alle bereitgestellten Kontaktinformationen werden in Übereinstimmung mit unserer Datenschutzrichtlinie aufbewahrt. Datenschutzrichtlinie.
Haben Sie Verbesserungsvorschläge?